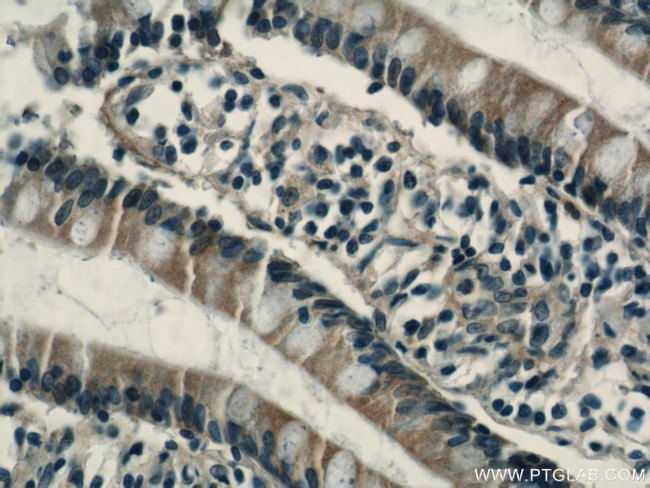
RHOF Antibody in Immunohistochemistry (Paraffin) (IHC (P))
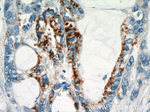
RHOF Antibody in Immunohistochemistry (Paraffin) (IHC (P))

Search
Proteintech
RHOF Polyclonal Antibody
{{$productOrderCtrl.translations['antibody.pdp.commerceCard.promotion.promotions']}}
{{$productOrderCtrl.translations['antibody.pdp.commerceCard.promotion.viewpromo']}}
{{$productOrderCtrl.translations['antibody.pdp.commerceCard.promotion.promocode']}}: {{promo.promoCode}} {{promo.promoTitle}} {{promo.promoDescription}}. {{$productOrderCtrl.translations['antibody.pdp.commerceCard.promotion.learnmore']}}
产品信息
12290-1-AP
种属反应
宿主/亚型
分类
类型
抗原
偶联物
形式
浓度
规格
纯化类型
保存液
内含物
保存条件
运输条件
产品详细信息
Immunogen sequence: MDAPGALAQ TAAPGPGRKE LKIVIVGDGG CGKTSLLMVY SQGSFPEHYA PSVFEKYTAS VTVGSKEVTL NLYDTAGQED YDRLRPLSYQ NTHLVLICYD VMNPTSYDNV LIKWFPEVTH FCRGIPMVLI GCKTDLRKDK EQLRKLRAAQ LEPITYMQVG RGQDPGAQPW L (1-170 aa encoded by BC018208)
靶标信息
Plasma membrane-associated small GTPase which cycles between an active GTP-bound and an inactive GDP-bound state. Causes the formation of thin, actin-rich surface projections called filopodia. Functions cooperatively with CDC42 and Rac to generate additional structures, increasing the diversity of actin-based morphology.
仅用于科研。不用于诊断过程。未经明确授权不得转售。
篇参考文献 (0)
生物信息学
蛋白别名: induced in fatty liver dystrophy 1; ras homolog family member F (in filopodia); ras homolog gene family, member F (in filopodia); Rho family GTPase Rif; Rho in filopodia; Rho-related GTP-binding protein RhoF; unnamed protein product
基因别名: AI845056; ARHF; AV026554; Ifld1; RHOF; RIF
UniProt ID: (Human) Q9HBH0, (Mouse) Q8BYP3
Entrez Gene ID: (Human) 54509, (Rat) 690130, (Mouse) 23912